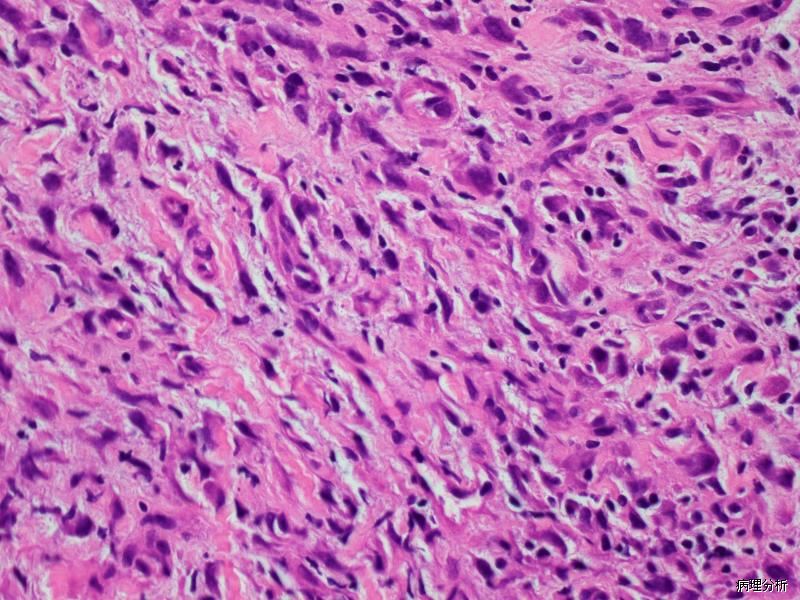
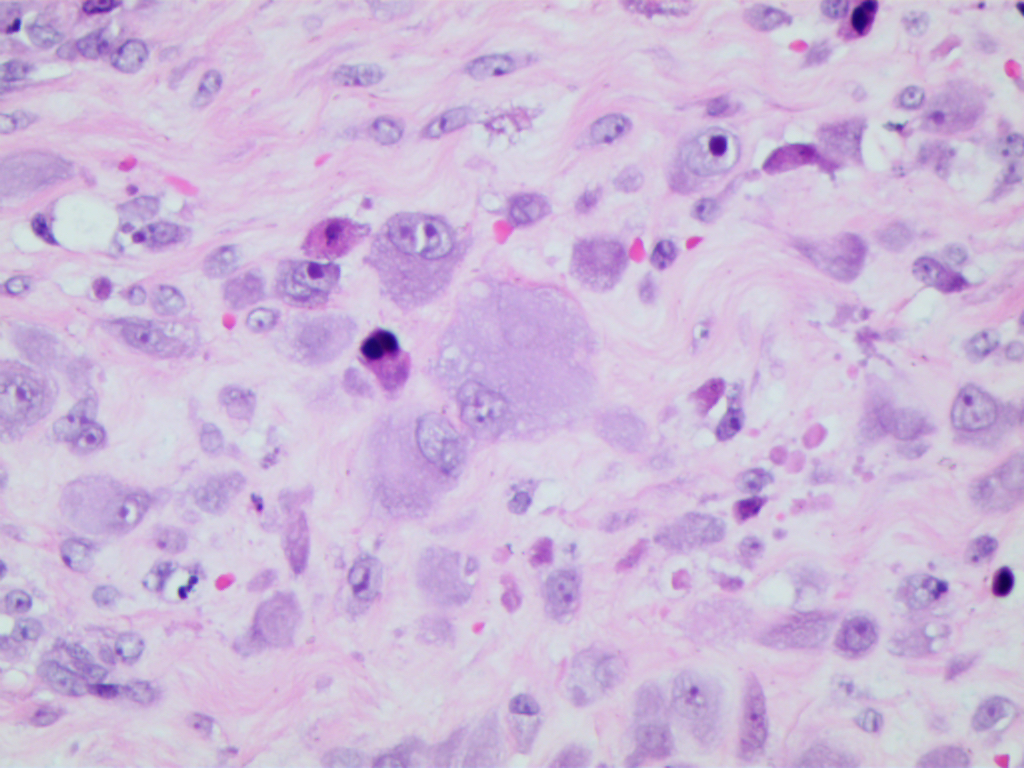
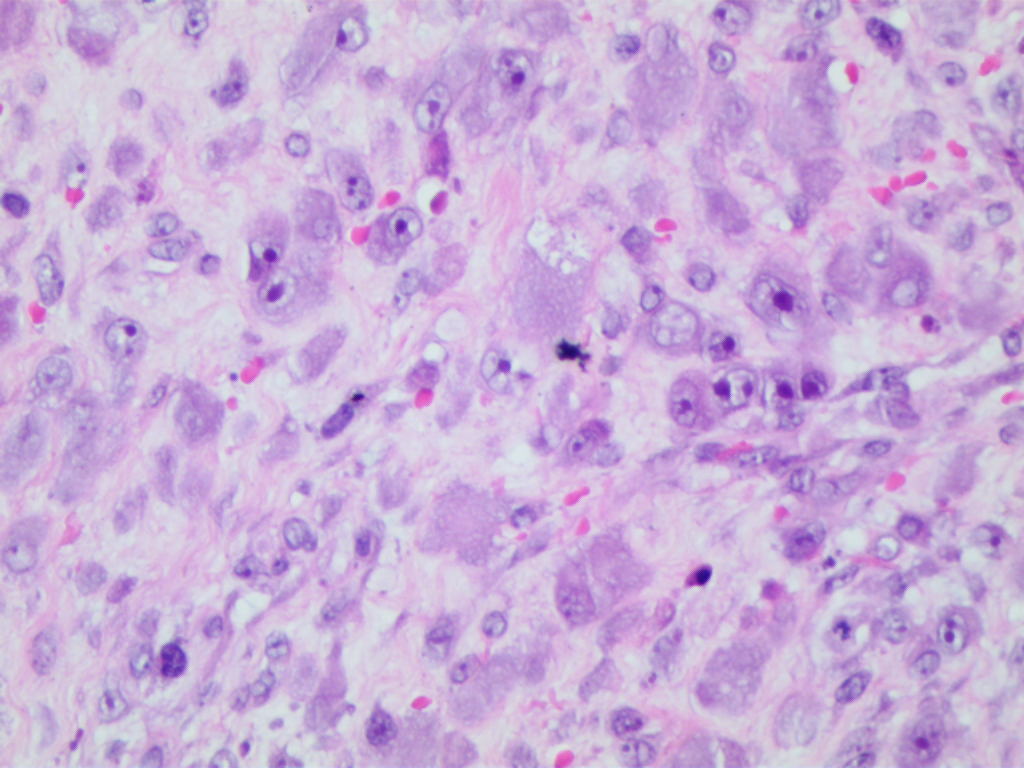

增生性肌炎
Proliferative Myositis
概述:
发生于筋膜、皮下的结节状纤维母细胞/肌纤维母细胞性增生性病变
发病部位: 四肢的皮下,以上臂最为多见,其次为大腿,躯干也可发生,头颈部少见
诊断要点:
好发于中老年人,少数发生于儿童,常见于四肢,主要累及骨骼肌;
由大量增生的纤维母细胞、肌纤维母细胞、节细胞样细胞和形态上介于两者之间的过渡形细胞组成;
纤维母细胞、肌纤维母细胞呈梭形或胖梭形,也可呈蝌蚪状和不规则形,核膜厚,染色质呈空泡状,可见核仁,核分裂像多少不等,但无病理性核分裂;
节细胞样细胞体积较大,呈多边形或不规则形,胞质丰富,双染性至嗜碱性,核大,圆形或卵圆形,常偏向胞质一侧,核膜厚,可见 1 ~ 2 个深蓝色散在或成群分布于纤维母细胞或脂肪细胞之间,有些细胞核仁突出,呈紫色包涵体样,致细胞呈核枭眼样;
间质含有多少不等的黏液样物质和胶原纤维;
病变穿插于横纹肌纤维之间,在横切面上常形成“棋盘”样,不累及横纹肌纤维本身;
部分病例内可伴有骨化,类似骨化性肌炎。

免疫组织化学染色:
vimentin、α-SMA 和 MSA 阳性,节细胞样细胞可弱表达 actins;S100 蛋白、desmin、myogenin 常阴性。
鉴别诊断:
增生性筋膜炎:无棋盘样结构。
横纹肌肉瘤:可见非典型核分裂象,免疫组化染色表达 desmin 和 Myod1, myogenin 等。
治疗:
病变完整切除
病例报道:
Benign proliferative myositis of the sternohyoid muscle: review and case report.
Colombo JR, Dagher W, Wein RO.
Am J Otolaryngol. 2015 Jan-Feb;36(1):87-9. doi: 10.1016/j.amjoto.2014.08.013. Epub 2014 Aug 30. Review.
参考文献:
Proliferative myositis** . Report of thirty-three cases.
Enzinger FM, Dulcey F.
Cancer. 1967 Dec;20(12):2213-23.
